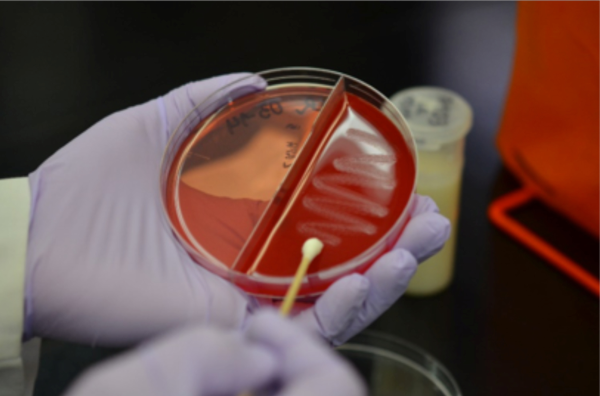

Quinn Kolar
Major Professor
Pamela Ruegg
Related Work
-
Advances in understanding Gram-positive mastitis on farms
Published on June 12, 2024
-
Animal Science 2021 Graduate Student Awards
Published on April 12, 2021

Print
Print Email
Email